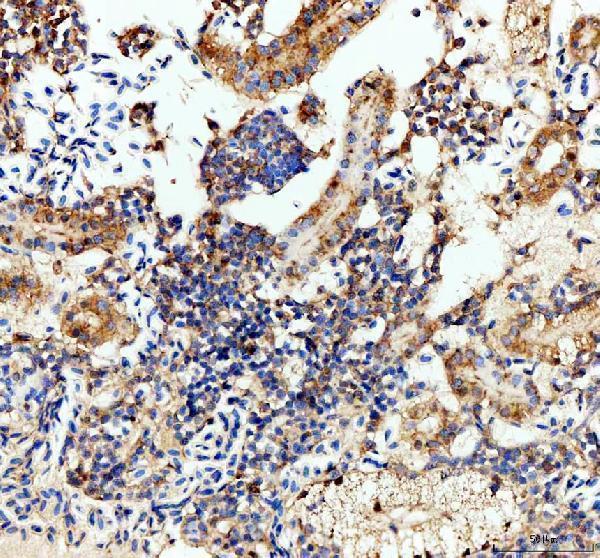
azq6tcf5 lhb primary antibodies ihc testing 5

Product Info Summary
| SKU: | AZQ6TCF5 |
|---|---|
| Size: | 100 μg/vial |
| Reactive Species: | Zebrafish |
| Host: | Rabbit |
| Application: | IHC |
Customers Who Bought This Also Bought
Product info
Product Name
Anti-Zebrafish LHB Antibody
SKU/Catalog Number
AZQ6TCF5
Size
100 μg/vial
Form
Lyophilized
Description
Boster Bio Anti-Zebrafish LHB Antibody catalog # AZQ6TCF5. Tested in IHC applications. This antibody reacts with Zebrafish.
Storage & Handling
At -20°C for one year from date of receipt. After reconstitution, at 4°C for one month. It can also be aliquotted and stored frozen at -20°C for six months. Avoid repeated freezing and thawing.
Cite This Product
Anti-Zebrafish LHB Antibody (Boster Biological Technology, Pleasanton CA, USA, Catalog # AZQ6TCF5)
Host
Rabbit
Contents
Each vial contains 4 mg Trehalose, 0.9 mg NaCl, 0.2 mg Na2HPO4.
Clonality
Polyclonal
Immunogen
E.coli-derived Zebrafish LHB recombinant protein (Position: L24-Y140)
Reactive Species
AZQ6TCF5 is reactive to LHB in Zebrafish
Background of LHB
Enables hormone activity. Acts upstream of or within several processes, including female gonad development; oocyte maturation; and ovulation. Predicted to be located in extracellular region. Predicted to be active in cytoplasm and extracellular space. Is expressed in several structures, including endocrine system; female organism; kidney; liver; and male organism. Human ortholog(s) of this gene implicated in hypogonadotropic hypogonadism 23 with or without anosmia. Orthologous to several human genes including LHB (luteinizing hormone subunit beta).
Antibody Validation
Boster validates all antibodies on WB, IHC, ICC, Immunofluorescence, and ELISA with known positive control and negative samples to ensure specificity and high affinity, including thorough antibody incubations.
Application & Images
Applications
AZQ6TCF5 is guaranteed for IHC Boster Guarantee
Recommend Dilution
| Application | Dilution | Species |
|---|---|---|
| Immunohistochemistry(Paraffin-embedded Section) | 2-5 μg/ml | Zebrafish |
Validation Images & Assay Conditions

Click image to see more details
IHC analysis of LHB using anti-LHB antibody (AZQ6TCF5).
LHB was detected in a paraffin-embedded section of zebrafish hypophysis tissue. Heat mediated antigen retrieval was performed in EDTA buffer (pH 8.0, epitope retrieval solution). The tissue section was blocked with 10% goat serum. The tissue section was then incubated with 2 μg/ml rabbit anti-LHB Antibody (AZQ6TCF5) overnight at 4°C. Peroxidase Conjugated Goat Anti-rabbit IgG was used as secondary antibody and incubated for 30 minutes at 37°C. The tissue section was developed using HRP Conjugated Rabbit IgG Super Vision Assay Kit (Catalog # SV0002) with DAB as the chromogen.

Click image to see more details
IHC analysis of LHB using anti-LHB antibody (AZQ6TCF5).
LHB was detected in a paraffin-embedded section of zebrafish hypothalamus tissue. Heat mediated antigen retrieval was performed in EDTA buffer (pH 8.0, epitope retrieval solution). The tissue section was blocked with 10% goat serum. The tissue section was then incubated with 2 μg/ml rabbit anti-LHB Antibody (AZQ6TCF5) overnight at 4°C. Peroxidase Conjugated Goat Anti-rabbit IgG was used as secondary antibody and incubated for 30 minutes at 37°C. The tissue section was developed using HRP Conjugated Rabbit IgG Super Vision Assay Kit (Catalog # SV0002) with DAB as the chromogen.

Click image to see more details
IHC analysis of LHB using anti-LHB antibody (AZQ6TCF5).
LHB was detected in a paraffin-embedded section of zebrafish ovary tissue. Heat mediated antigen retrieval was performed in EDTA buffer (pH 8.0, epitope retrieval solution). The tissue section was blocked with 10% goat serum. The tissue section was then incubated with 2 μg/ml rabbit anti-LHB Antibody (AZQ6TCF5) overnight at 4°C. Peroxidase Conjugated Goat Anti-rabbit IgG was used as secondary antibody and incubated for 30 minutes at 37°C. The tissue section was developed using HRP Conjugated Rabbit IgG Super Vision Assay Kit (Catalog # SV0002) with DAB as the chromogen.

Click image to see more details
IHC analysis of LHB using anti-LHB antibody (AZQ6TCF5).
LHB was detected in a paraffin-embedded section of zebrafish testis tissue. Heat mediated antigen retrieval was performed in EDTA buffer (pH 8.0, epitope retrieval solution). The tissue section was blocked with 10% goat serum. The tissue section was then incubated with 2 μg/ml rabbit anti-LHB Antibody (AZQ6TCF5) overnight at 4°C. Peroxidase Conjugated Goat Anti-rabbit IgG was used as secondary antibody and incubated for 30 minutes at 37°C. The tissue section was developed using HRP Conjugated Rabbit IgG Super Vision Assay Kit (Catalog # SV0002) with DAB as the chromogen.
Click image to see more details
IHC analysis of LHB using anti-LHB antibody (AZQ6TCF5).
LHB was detected in a paraffin-embedded section of zebrafish kidney tissue. Heat mediated antigen retrieval was performed in EDTA buffer (pH 8.0, epitope retrieval solution). The tissue section was blocked with 10% goat serum. The tissue section was then incubated with 2 μg/ml rabbit anti-LHB Antibody (AZQ6TCF5) overnight at 4°C. Peroxidase Conjugated Goat Anti-rabbit IgG was used as secondary antibody and incubated for 30 minutes at 37°C. The tissue section was developed using HRP Conjugated Rabbit IgG Super Vision Assay Kit (Catalog # SV0002) with DAB as the chromogen.
Specific Publications For Anti-Zebrafish LHB Antibody (AZQ6TCF5)
Loading publications
Recommended Resources
Here are featured tools and databases that you might find useful.
- Boster's Pathways Library
- Protein Databases
- Bioscience Research Protocol Resources
- Data Processing & Analysis Software
- Photo Editing Software
- Scientific Literature Resources
- Research Paper Management Tools
- Molecular Biology Software
- Primer Design Tools
- Bioinformatics Tools
- Phylogenetic Tree Analysis
Customer Reviews
Have you used Anti-Zebrafish LHB Antibody?
Share your experimental results or join a short interview to earn up to $1,000 in product credits or other rewards.
0 Reviews For Anti-Zebrafish LHB Antibody
Customer Q&As
Have a question?
Find answers in Q&As, reviews.
Can't find your answer?
Submit your question





